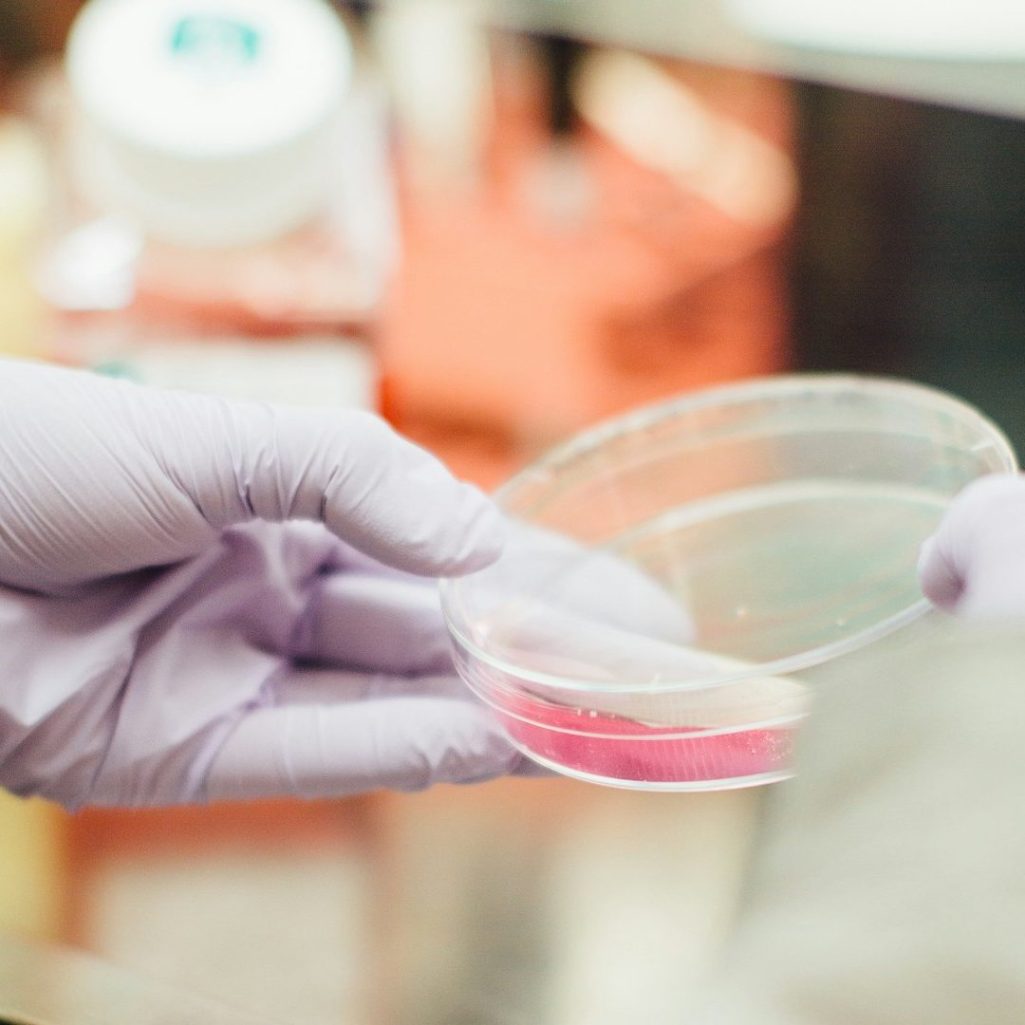

Wir bieten umfassende medizinische Check-ups und Behandlungen für Patienten aus Nigeria. Genießen Sie eine stressfreie Zeit in unseren erstklassigen Einrichtungen.
Wir bieten Ihnen:
medizinische Check-ups und Behandlungen in Deutschland für Patienten aus Nigeria.
Medizinischer Tourismus mit einem breiten Spektrum an Abteilungskapazitäten.
Wir organisieren Ihr Visum und holen Sie am Flughafen ab.
Wir kümmern uns um Ihre Unterkunft und den Aufenthalt im Krankenhaus.
Unser Ziel ist es, Ihren Aufenthalt in Deutschland so komfortabel und stressfrei wie möglich zu gestalten.

Behandelte Patienten
Dienstleistungen
Zufriedene Kunden
Umfassende Untersuchungen für Ihre Gesundheit und Ihr Wohlbefinden.


Modernste Diagnosetechniken für Herz-Kreislauf-Erkrankungen.


©Urheberrecht. Alle Rechte vorbehalten.
Wir benötigen Ihre Zustimmung zum Laden der Übersetzungen
Wir nutzen einen Drittanbieter-Service, um den Inhalt der Website zu übersetzen, der möglicherweise Daten über Ihre Aktivitäten sammelt. Bitte überprüfen Sie die Details in der Datenschutzerklärung und akzeptieren Sie den Dienst, um die Übersetzungen zu sehen.